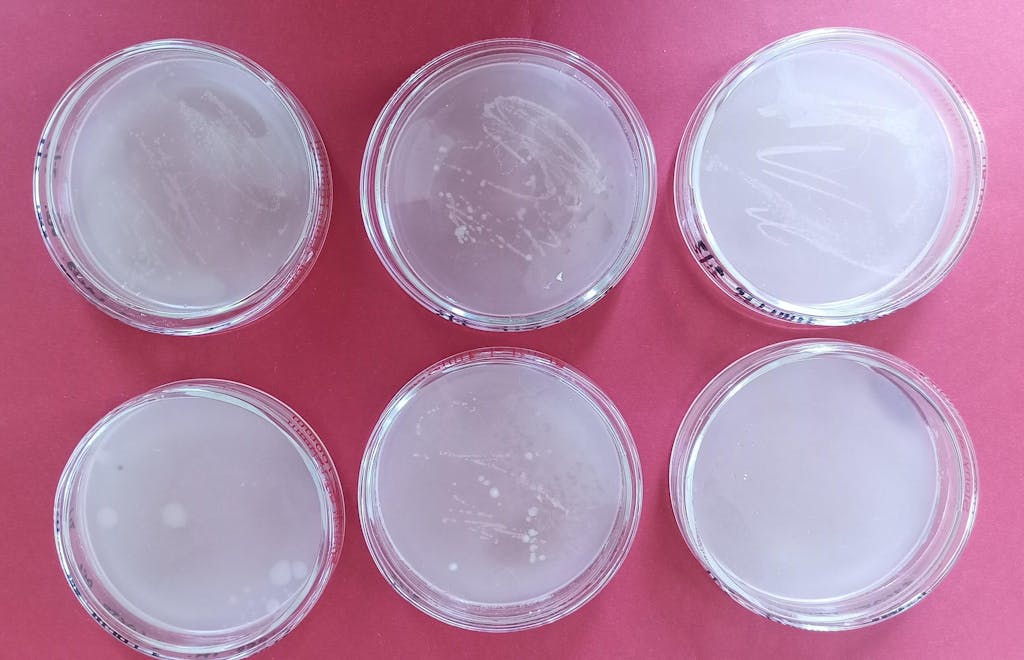

SKU:
Glass Petri Dishes with Clear Lid, 60-120 mm
Glass Petri Dishes with Clear Lid, 60-120 mm
Tax-free for all U.S. orders except New York.
NY Tax-Exempt organization? Contact us.
About this item
-
Material: borosilicate glass for chemical resistance and thermal stability
-
Sizes available: 60 mm × 15 mm, 75 mm × 15 mm, 90 mm × 20 mm, 100 mm × 20 mm
-
Intended Use: suitable for microbial culture, plant germination, cell culture, precipitate drying, and general laboratory use
-
Autoclavable: withstands 121 °C at 15 psi for sterilization without deformation
-
Warranty: stonylab 1-year limited warranty; contact us for replacement if damaged
Couldn't load pickup availability
1-Year FREE Warranty
1-Year FREE Warranty
Rest easy knowing that all web registered members receive a 1 year of full coverage on all purchases, with additional protection options available for equipment.
FREE Return
FREE Return
Enjoy 30-day free return on most regular orders. Check our Return Policy for full details and easy return steps.
FREE US Shipping
FREE US Shipping
All continental US orders enjoy free standard shipping.
Best Price Promise
Best Price Promise
Buy with confidence! Our 10-day Price Adjustment policy ensures you get the best deal.
Contact Us
Contact Us
100% Satisfaction! Please feel free to contact us anytime. All your questions will be answered within timely manner.
Secure Payment
Secure Payment
All transactions are protected by advanced encryption to ensure your personal and payment information stays safe.

























First, this is a great company to do business with. Second, the 5 pack of 75 x 15 mm petri dishes arrived well packaged and individually wrapped in a multicompartment foam shipping container. All ten pieces were in perfect condition. This container also serves as a perfect storage container. Third, these dishes are well made, and likely will last a long time. Fourth, when purchased in a 5 pack, they are an excellent value. Last, these are a much better choice than disposable plastic dishes.
Only one lid was broken, but I am using them for watercolor pans so did not bother me. The remaining 19 are perfectly beautiful!
I had purchased other petri dishes made of glass before, and had a problem with them cracking. However, these petri dishes arrived in an oversized box with about a half inch of foam padding around each one. They hold up very well to re-processing and autoclaveing.
After ordering a few different brands of petri dishes from Amazon, this one is by far the best. The others were poorly packed and came with at least one broken dish. This is packed very well. The top and bottom fit well. A green alternative to disposable dishes. I sterilize and pour agar in my oven .
Best Seller
-
StonyFilm Lab Sealing Film, 10 cm Wide x 38 m Long, High Stretchability >500%
Regular price $23.49 USDRegular priceUnit price / per$24.99 USDSale price $23.49 USDSale -
Glass Beaker, 50-5000 ml
Regular price From $7.60 USDRegular priceUnit price / per$8.09 USDSale price From $7.60 USDSale -
Forced Air Drying Oven, 30-1000 L, RT-250°C
Regular price $1,490.00 USDRegular priceUnit price / per -
High-Low Temperature Circulator, 3-9 L, -80~100°C, 12-22 L/min Circulation Flow Rate
Regular price From $1,899.00 USDRegular priceUnit price / per -
Filtering Flask, Bolt Neck with Tubulation, 50-5000 ml
Regular price From $14.09 USDRegular priceUnit price / per$14.99 USDSale price From $14.09 USDSale
- Choosing a selection results in a full page refresh.
- Opens in a new window.